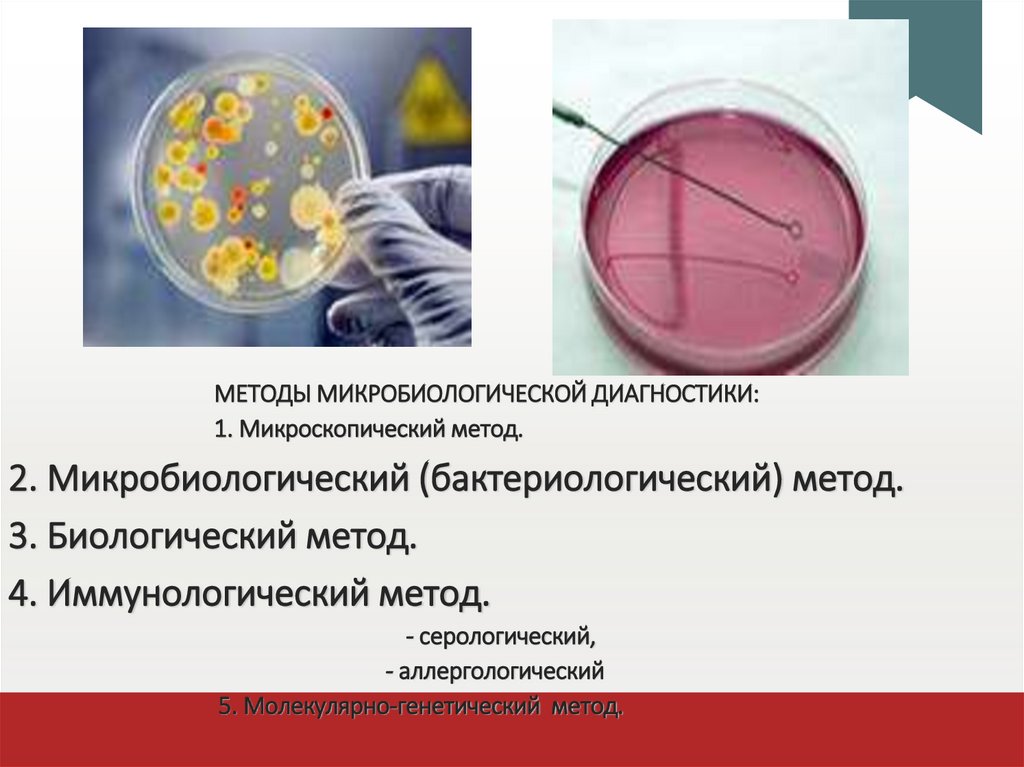

Похожие презентации:
становление_микробиологии_как_науки
1.
СТАНОВЛЕНИЕ МИКРОБИОЛОГИИ КАКНАУКИ
Выполнила: студентка 141 группы
Ешидоржиева Арина
2.
Введение:1. Микробиология как наука:
• предмет ее изучения.
• значение микроорганизмов в жизни человека.
2. Исторические этапы развития микробиологии.
3. Вклад ученых в развитие микробиологии.
4. Медицинская микробиология:
- задачи медицинской микробиологии.
- методы микробиологической диагностики.
3.
• МИКРОБИОЛОГИЯ(от micros — малый, bios — жизнь, logos — учение)
наука, изучающая закономерности жизни и развития
мельчайших организмов — микроорганизмов в их
единстве со средой обитания.
4.
значение микроорганизмов в жизни человека.Природные процессы: Участвуют в круговороте веществ и
энергии, формируют атмосферу, почву, способствуют
образованию полезных ископаемых (нефть, уголь),
выветриванию пород.
Хозяйственное значение: Производят пищевые продукты
(хлеб, вино, пиво, молочные продукты), органические
кислоты,
витамины,
ферменты,
белки,
гормоны,
аминокислоты, антибиотики и лекарства.
Экология: Очищают окружающую среду от загрязнений,
поддерживают здоровье человека (эндоэкология).
Взаимодействие: Являются движущей силой в развитии
защитных систем организмов, но также могут вызывать
заболевания.
5.
Развитие микробиологии дало толчок развитиюбиохимии,
генетики,
молекулярной биологии,
генной инженерии.
6.
ИСТОРИЧЕСКИЕ ЭТАПЫ РАЗВИТИЯМИКРОБИОЛОГИИ:
1.
2.
3.
4.
5.
6.
Период эмпирических знаний.
Морфологический период.
Физиологический период.
Иммунологический период.
Период открытия антибиотиков.
Современный молекулярно- генетический этап.
7.
1. ПЕРИОД ЭМПИРИЧЕСКИХ ЗНАНИЙ.догадки о живом возбудителе высказывали
Тит Лукреций Кар (95—55 гг. до н. э.),
Клавдий Гален (131— 201 гг. н. э.),
Ибн Сина (980—1037)
Фракасто́ро Джироламо (1478—1553)
предположил живую природу агентов
инфекционных заболеваний –
contagium vivum.
«О контагии, о контагиозных болезнях и
лечении»
систематическое учение
об инфекции и путях её передач
8.
2. МОРФОЛОГИЧЕСКИЙ ПЕРИОД.1610 год, Галилео Галилей
создание первого микроскопа
1665 год, Роберт Гук,
впервые увидел
растительные клетки.
9.
1675 год,Антони ван Левенгук первооткрыватель микромира.
Он сумел изготовить двояковыпуклые
линзы, дававшие увеличение в 150—
300 раз.
Левенгук считал обнаруженных им
микроскопических существ «очень
маленькими животными» и
приписывал им те же особенности
строения и поведения, что и
обычным животным. впервые
описал простейших и основные
формы бактерий.
10.
Микроскоп 1751 годаСовременный световой микроскоп
11.
3. ФИЗИОЛОГИЧЕСКИЙ ПЕРИОД- золотой век микробиологии (с XVII по XIX век)
Луи Пастер (1822—1895)
«Микробы - бесконечно малые
существа, играющие в природе
бесконечно большую роль».
- развитие промышленной микробиологии,
- выяснение роли микроорганизмов в кругообороте веществ в природе,
- открытие анаэробных микроорганизмов,
- разработка принципов асептики, методов стерилизации,
- ослабления (аттенуации) вирулентности микроорганизмов и получения
вакцин (вакцинных штаммов) в частности от сибирской язвы , бешенства .
- получения чистых культур бактерий,
- изучение возбудителей сибирской язвы, холеры, бешенства и др.болезней.
12.
Mycobacteriumtuberculosis
Генрих Герман Роберт Кох (1843 – 1910)
-метод выделения чистых культур на твердых питательных средах (ввел в
практику чашки Петри)
- способы окраски бактерий анилиновыми красителями,
- открытие возбудителей сибирской язвы, холеры, туберкулеза –
- совершенствование техники микроскопии.
- экспериментальное обоснование постулатов (триада) Хенле- Коха.
• возбудитель заболевания должен регулярно обнаруживаться у пациента
• он должен быть выделен в чистую культуру
• выделенный микроорганизм должен вызывать у подопытных животных те
же симптомы, что и у больного человека
Нобелевская премия по физиологии и медицине в 1905 за исследования
туберкулёза.
13.
РУССКИЕ МИКРОБИОЛОГИЦенковский Лев Семенович
(1802-1887)
русский ботаник, протозоолог и
бактериолог, один из
основоположников онтогенетического
метода в изучении низших растений и
низших животных, развил
представление о генетическом
единстве растительного и животного
мира.
14.
Виноградский Сергей Николаевич(1856 – 1953)
русский микробиолог, эколог, почвовед,
основатель экологии микроорганизмов и
почвенной микробиологии.
Гамалея Николай Фёдорович
(1859 – 1949)
русский советский ученый-микробиолог,
эпидемиолог, врач.
15.
Габричевский ГеоргийНорбертович(1860—1907)
русский ученый-микробиолог,
эпидемиолог, организатор
отечественной бактериологической
науки и образования.
Омелянский Василий
Леонидович (1867 – 1928)
русский советский микробиолог.
Основные труды посвящены изучению
роли микробов в круговороте веществ
(углерода и азота)
16.
4. ИММУНОЛОГИЧЕСКИЙ ПЕРИОДЭдвард Дженнер (1729 – 1823)
в 1796 г. доказал, что прививка
людям коровьей оспы создает
невосприимчивость
к натуральной оспе.
Илья Ильич Мечников (1845—1916)
“поэт микробиологии” (Эмиль Ру)
разработал теорию фагоцитоза и
обосновал клеточную теорию
иммунитета.
17.
Пауль Эрлих (1854 – 1915)разработал гуморальную теорию иммунитета
В последующей многолетней и плодотворной дискуссии между сторонниками
фагоцитарной и гуморальной теорий были раскрыты многие механизмы
иммунитета и родилась наука - Иммунология
И.И.Мечникову и П.Эрлиху в 1908г. была присуждена Нобелевская премия.
18.
В 1892 г. на заседании Российской академии наук Д.И.Ивановский сообщил,что возбудителем мозаичной болезни табака является фильтрующийся
вирус.
Эту дату можно считать днем рождения вирусологии, а Д.И.Ивановского - ее
основоположником.
а
я
Дмитрий Иосифович Ивановский
(1863—1920)
19.
5. ОТКРЫТИЕ АНТИБИОТИКОВА. Флеминг в 1928 г. наблюдал зоны лизиса стафилококка в чашках, случайно
проросших зеленой плесенью. Выделенный штамм плесени губительно
действовал и на другие микробы.
Рenicillium
Александр Флеминг (1881 – 1955) английский
20.
Чейн Эрнст Борис(1906 - 1979),
Флори Хоуард Уолтер
(1898 – 1968),
английский биохимик,
английский патолог и микробиолог
• В 1938 году получили пенициллин в пригодном для инъекций виде.
.
• Нобелевская премия
по физиологии и медицине в 1945 году
совместно с Александром Флемингом за открытие и синтез
пенициллина.
21.
Первый отечественный пенициллин (крустозин)был получен З.В. Ермольевой
из P. crustosum в 1942 г.
Зинаида Виссриновна Ермольева (1898 – 1974)
22.
6. СОВРЕМЕННЫЙ МОЛЕКУЛЯРНО- ГЕНЕТИЧЕСКИЙ ЭТАП(вторая половина ХХ века)
• достижения генетики и молекулярной биологии,
• создание электронного микроскопа.
• доказательство роли ДНК в передаче наследственных признаков.
• использование бактерий, вирусов и плазмид в качестве объектов
молекулярно- биологических и генетических исследований
23.
Медицинская микробиологияизучает микроорганизмы, вызывающие заболевания
человека (их морфологию, физиологию, экологию,
биологические и генетические характеристики), а также
процессы, происходящие в организме при внедрении
болезнетворных микроорганизмов.
разрабатывает методы их культивирования и
идентификации, специфические методы их
диагностики, лечения и
профилактики
24.
Медицинская микробиология1.Общая
рассматривает
свойства
микроорганизмов и их взаимодействие с
организмом хозяина.
2.Частная
- характеризует возбудителей
отдельных болезней и методы их лабораторной
диагностики
25.
Из медицинской микробиологии выделены:• Вирусология – наука о вирусах
• Протозоология – наука о простейших
• Микология – наука о грибах
• Иммунология - изучает защитные процессы,
происходящие в организме
• Санитарная микробиология – изучает
микроорганизмы, обитающие во внешней среде
• Клиническая - роль УПМ в возникновении заболеваний
человека, диагностика и профилактика
• Фармацевтическая - исследует технологию
получения микробиологических и иммунологических
диагностических, профилактических и лечебных
препаратов.
26.
Задачи медицинской микробиологии:1. Изучение роли микроорганизмов (в норме и патологии).
2. Выявление и характеристика микробов.
3. Разработка методов диагностики, профилактики и лечения инфекций.
4. Бактериологический контроль (среды, пищи, стерильности, источников
инфекции).
5. Контроль чувствительности микробов к антибиотикам и состояния
микробиоценозов.
27.
Основные задачимедицинской микробиологии
Изучить:
• свойства патогенных для человека МО;
• механизмы развития инфекции;
Разработать:
• методы лабораторной диагностики;
• методы специфической терапии и профилактики
заболеваний, вызываемых МО.
28.
Перспективы развития.•микробиология, вирусология и иммунология - одно из ведущих направлений
биологии и медицины;
•иммунология подошла к регулированию механизмов самозащиты организма,
коррекции иммунодефицитов, решению проблемы СПИДа, борьбе с
онкозаболеваниями;
•создаются новые генно- инженерные вакцины;
•Появляются новые данные об инфекционных агентах, вызывающих
"соматические" заболевания, такие как язвенная болезнь, гастриты, гепатиты,
инфаркт миокарда, склероз, бронхиальная астма и шизофрения др.
•Появились новые и возвращающиеся инфекции (микобактерии туберкулеза,
ВИЧ, легионеллы и др.).
•открыты вироиды и прионы - новые классы инфекционных агентов.
29.
МЕТОДЫ МИКРОБИОЛОГИЧЕСКОЙ ДИАГНОСТИКИ:1. Микроскопический метод.
2. Микробиологический (бактериологический) метод.
3. Биологический метод.
4. Иммунологический метод.
- серологический,
- аллергологический
5. Молекулярно-генетический метод.
30.
1. МИКРОСКОПИЧЕСКИЙ МЕТОД• Микроскопические исследования
носят ориентировочный характер изза отсутствия у многих
микроорганизмов чётких
морфологических и тинкториальных
особенностей. Однако, микроскопия
позволяет выявить некоторые
признаки возбудителей и установить
наличие или отсутствие
микроорганизмов в образцах.
31.
2. МИКРОБИОЛОГИЧЕСКИЙ(БАКТЕРИОЛОГИЧЕСКИЙ) МЕТОД
• «золотой стандарт» микробиологической
диагностики, результаты микробиологических
исследований позволяют точно установить
факт наличия возбудителя в исследуемом
материале.
Идентификацию чистых культур проводят до
вида микроорганизма.
32.
3. БИОЛОГИЧЕСКИЙ МЕТОД• Моделирование экспериментальных
инфекций у лабораторных животных —
важный инструмент изучения патогенеза
заболевания и характера
взаимодействий микроорганизма и
макроорганизма.
33.
4. ИММУНОЛОГИЧЕСКИЙ МЕТОД(серологический)
• Выявления специфических AT и АГ — важный
инструмент в диагностике инфекционных
заболеваний. Особую ценность они имеют в тех
случаях, когда выделить возбудитель не
представляется возможным.
34.
5. МОЛЕКУЛЯРНО-БИОЛОГИЧЕСКИЙ МЕТОД• Одним из самых современных методов
молекулярной биологии является метод ПЦР –
полимеразная цепная реакция. Исследование
методом ПЦР имеет ряд преимуществ, так как
данный метод позволяет увеличивать
(амплифицировать) в сотни раз участок ДНК
возбудителя заболевания в исследуемом образце.
Метод ПЦР имеет высокую чувствительность и
абсолютную специфичность.
35.
ВЫВОДДостижения микробиологических наук позволили изучить
фундаментальные
процессы
жизнедеятельности
микроорганизмов на молекулярно - генетическом уровне.
Они обусловливают современное понимание сущности
механизмов развития многих заболеваний и направления их
более эффективного предупреждения и лечения

Биология
Биология








